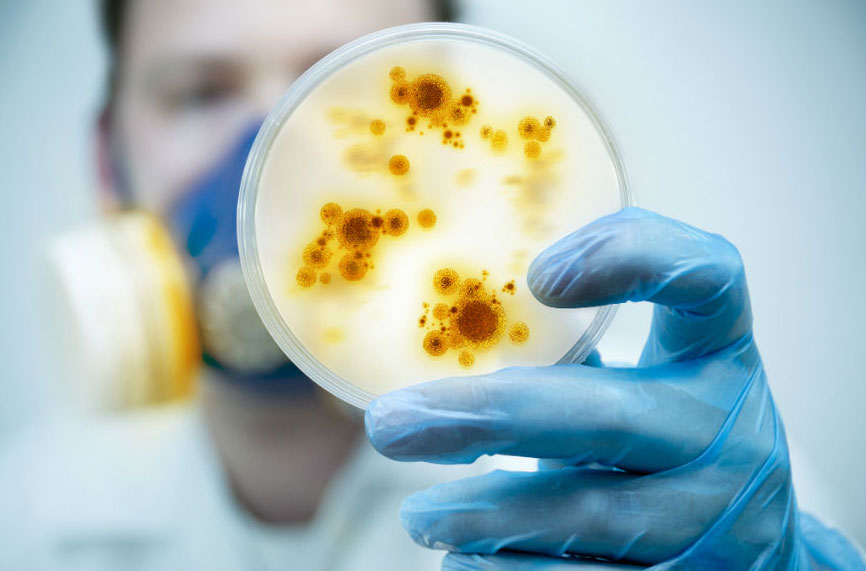

Д-р Тодор Хинов
ИНФЕКЦИЯТА се среща ежедневно с всеки от нас като се опитва да ни победи, но засега човечеството се справя с различни методи.
Кои са причинителите на инфекцията?
– бактерии
– вируси
– гъбички
– паразити
– приони
БАКТЕРИИТЕ СА НАЙ-ПРОУЧВАНИТЕ МИКРООРГАНИЗМИ. Те са разделени в различни групи според техните свойства, оцветяване, среда на живот (кислородна и безкислородна) и други. Те се разделят на подвидове като коки, бацили, с наличие на спори или не и т.н. Бактериите се влияят от антибиотици. Те причиняват тежки инфекции, които в някои случаи са смъртоносни. Лечението при бактериална инфекция е с антибиотици, тъй като те се влияят само от тях.
ВИРУСИТЕ – най-често целогодишно обикалят вътрешната среда на човека, както и околната среда, в която живеем. Такива са херпес вирусите, вирусите на варицелата (зона), EBV – епщайн бар вирус, причинител на инфекциозната мононуклеоза, CMV – цитомегаловирус и много други групи вируси например папилома вируси, грипни вируси(А,В и C), вируси от групата на корона (очаквайте в следващия брой).
ГЪБИЧКИ – причиняващи различни заболявания, като най-често срещани са аспергилоза, кандидоза, споротрихоза, дерматофитоза и други. Много честно гъбичните инфекции се развиват след продължително лечение с антибиотици. Те са упорити и при нарушен имунитет могат да причинят тежки инфекции.
ПАРАЗИТИ – от известните се представят с голямо разнообразие и присъствие както в човека,животните, така и в околната среда. Трудно се диагностицират като има малко методи, които да обективизират тяхното присъствие. Причиняват тежки хронични заболявания, които протичат бавно във времето. Диагнозата се поставя от анамнеза (подробен диалог), извършена насочено от подготвен лекар. В помощ се явяват кръвни, фекални, хистологични и функционални изследвания, както и биорезонансова диагностика. Всичко гореизброено се разглежда комплексно и упорито.
Част от заболяванията са:
– нематоди (кръгли червеи)
– цестоди (плоски червеи)
– трематоди (описторхоза, цистозоми, шистоматози, дистоматози и др.)
ПРИОНИ са последната известна група, причиняваща инфекции. Това са неконвенционални възбудители, свързани с един белтък, който нормално се синтезира от здравите хора (протеинов прион) и се намира на повърхността на невроните (нервни клетки). Свързва се с “болестта на лудата крава”.
Следващата тема ще бъде свързана с последните новости за профилактиката, диагностиката и лечението на вирусните инфекции (грипна и коронавирусна инфекции).